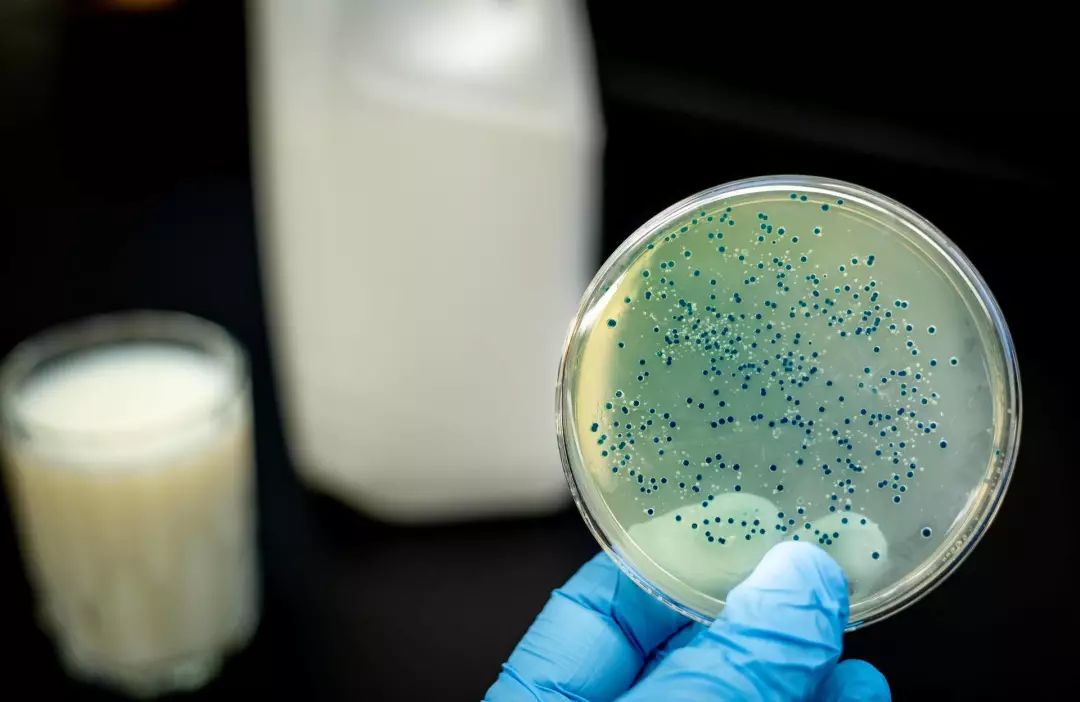
兰州兽研所布病会传染么,兰州兽研所布病感染

在实验室布鲁氏菌极易传播,应在安全防护服的充分保护下进行细菌学分析。图源:news.delaware.gov
撰文 | 汤佩兰
责编 | 陈晓雪
12月6日傍晚时分,中国农业科学院兰州兽医研究所(以下简称为“兰州兽研所”)官方微信公众号发布通报称,11月28到29日,该所口蹄疫防控技术团队先后报告有4名学生布鲁氏菌病血清学阳性。截至目前检测263人,经甘肃省疾控中心确认呈现血清学阳性65人,其中个别人员感到身体不适,其余人员未出现明显临床症状。[1]
当天,兰州市卫健委网站的消息称,这65人已均按照治疗方案进行医学观察,必要时及时采取规范治疗措施。[2]
目前,传染源尚未确定,具体的疫情调查工作还在进行之中。
01.65人布鲁氏菌病血清学呈阳性
根据兰州兽研所的通报,截至目前,共检测263人份,经甘肃省疾控中心确认布鲁氏菌病血清学阳性65人。
布鲁氏菌病,简称布病,是一种由布鲁氏菌侵入机体,引起传染-变态性反应的人畜共患传染病,与艾滋病、狂犬病、乙肝等被列为乙类传染病。急性期布病患者临床表现主要特征为发烧、多汗、关节肌肉痛、乏力等情况,慢性患者则表现为关节损害、长期发热等等。
在兰州兽研所正式发布通报前,12月5日关于 “兰州兽医研究所疑似近百名学生布病感染血清型阳性”的消息已经在网上流传。在网络问答平台知乎上有认证身份为中国农业科学院在读博士的网友称,最初是兽研所有学生在实验小鼠中检测发现布病抗体阳性。随后学生们前往医院进行抗体检查。
12月6日,《知识分子》联系兰州市疾控中心,询问兰州兽研所疑似布病的情况,其工作人员向《知识分子》确认,“我们的人都在现场,现在都回不来,他们现在每天都过去(现场)的。”
上述兰州兽研所发布的通报提到,在首例阳性发生后,兰州兽研所于11月29日组织学生进行诊治,同时成立调查小组,关闭相关实验室并开展调查。“目前,具体的疫源调查工作正在进行。”
兰州兽研所成立于1957年,是国内专门从事预防兽医学研究的知名科研单位之一,也是国内唯一的口蹄疫科学研究、诊断和咨询中心。据官网介绍,目前使用的实验动物包括普通实验兔、豚鼠、牛、羊、猪、鸡,还有面向其他科研、大专院校、医院、药厂等单位提供实验动物的业务。[3]
据央广网报道,甘肃农业大学学生表示兰州多所高校都会从兰州兽研所购买实验动物,也有其他高校学生在兽研所做短期实验,在病原未明情况下,相关学生也有陆续前往医院进行检查。[4]
02.传染如何发生?
目前,具体的疫源调查工作还在进行。那么,如此大规模的布病传染是如何发生的呢?
厦门大学附属翔安医院感染科主任医师付丽娟表示,布病不是人传染给人,而是动物,比如牛、羊、猪,传染给人,“通过呼吸道、消化道、皮肤接触的途径都可以传播”。通过消化道传播,具体来说,比如人们吃了含有布氏杆菌污染牛羊奶、奶酪或者进食未熟的牛羊肉等。而在实验室、屠宰场等地方,可以通过皮肤接触或者空气中含有布氏杆菌的气溶胶经呼吸道传播。
已知有60多动物(家畜、家禽、野生动物、驯化动物)均可作为布鲁氏菌的贮存宿主,疫畜是布鲁氏菌病的主要传染源,中国大部分地区以羊作为主要传染源,牛、猪、鹿、犬等动物也可成为传染源。[5]

疫畜是布鲁氏菌病的主要传染源。图源:CDC Global. Flickrhttps://www.flickr.com/photos/cdcglobal/17192151710
12月6日上午,甘肃省疾病预防控制中心发布的《布病知识大问答》提到,布氏菌实验室操作人员、皮毛加工企业职工、圈舍打扫容易通过呼吸道传播感染。[4]
对于网上流传的实验小鼠传染的说法,付丽娟认为需界定清楚,动物传染一般以牛、羊、猪为主,“啮齿类动物传播布氏杆菌少见。如果要是说这个鼠现在就感染了布氏杆菌,它的来源是我们给他接种的,还是通过其他方式感染的,一定是要界定清楚的。老鼠不应是(原始)传染源。” 付丽娟介绍,在动物实验过程中将各种病毒,细菌接种给鼠类,进行实验,将其解剖或采样检测是常用方法。
北京某三甲医院感染科副主任医师罗达(化名)也表示,“以前可能都没有想到老鼠会得布病,需要去调查这个问题出在哪”。他同时指出,实验鼠打小在实验室长大进行繁殖培养,理论上不应该感染。
12月6日,兰州市卫健委网站的消息称,根据抗体阳性,无相关临床症状,经流行病学、实验室检测和临床专家综合研判,确定最初上报4例疑似布病病例为布病隐性感染。
那么,什么是隐性感染?
中华人民共和国卫生行业标准-布鲁氏菌病诊断(WS 269—2019)显示,由于布鲁氏菌病临床表现多样,难以某一症状确定诊断。对布鲁氏菌病的诊断,需结合病人流行病学接触史、临床表现和实验室检查等情况综合判断。[5]
罗达向《知识分子》解释称,所谓隐性感染指的是没有临床症状,但是有确定诊断的实验阳性,并表示实验室初筛呈阳性确实不能作为确定诊断的标准,存在假阳性的可能。最终确诊的标准还是要通过试管凝集试验,滴度1:100及以上。“(很多人)可能有误解,觉得初筛抗体阳性就一定感染了。”
根据兰州兽研所的通报,目前血清学阳性人员中个别人员自感有身体不适现象,其余人员未出现明显临床症状。而据《新京报》报道,兰州兽研所一名研究员在接受采访中表示,抗体阳性不代表发病,抗体阳性但无任何症状者在医学上称为隐性感染者,超过潜伏期无症状就不会发病。[6]
在此次事件中,罗达还跟多位来自兰州兽研所的学生打过交道。他告诉《知识分子》,在本周三、四的时候,他所在科室接诊过至少十个来自兰州兽研所的学生做检查,据他们说 “做实验的动物有问题,想过来查一下”,但大部分人确实都没事,其中有一个是初筛阳性。
03.布病到底影响几何?
患过布病感染可能对身体造成什么影响?在临床上,感染布氏杆菌会出现发热,多汗,乏力,肝脾淋巴结肿大,关节受累,甚至局部脓肿,可以并发*丸睾**炎,卵巢炎等症状。
在常规临床治疗上,付丽娟提到“通常采用利福平和多西环素两个联合治疗”。根据2017年发布的《布鲁菌病诊疗专家共识》,治疗原则为早期、联合、足量、足疗程用药,必要时延长疗程,以防止复发及慢性化。[7]
付丽娟表示如果是急性感染,在完全把病菌清除、治疗彻底的情况下 “问题不大”。对于长期的慢性的感染者而言,关节骨的损伤会比较严重,“有的后期都会丧失劳动能力”。对于伴发*丸睾**炎,卵巢炎患者,可能会对生育功能有影响。急性期指病程6个月以内的感染,慢性感染指病程超过6个月仍未痊愈的感染。
罗达补充称,布病对动物生殖影响的研究很多,但会不会导致人的不孕不育,他还没有看到这方面的报道。“但是如果你正好是怀孕期间感染了,那是有可能导致流产、死胎。”他表示对于无临床症状的初筛阳性者,甚至现在还不够隐性感染者诊断标准的人是不是要早期干预、早期治疗,现在还没有一个统一的结论。
自建国以后开展疫情监测,布病一直是主要检测人畜共患传染病之一;2005年起,中国疾病控制中心(CDC)将布病纳入全国重点传染病检测工作。[8] 关宏等人在《2018年甘肃省人间布鲁氏菌病疫情分析》中提到,作为畜牧养殖业大省,2000年以后布病新发病人区域增加,发病率呈上升趋势。以2018年为例,布病新发病人1581例,是全国布鲁氏菌病流行较为严重的省份之一。感染病例职业分布上,主要以从事养殖业、畜牧业的农民为主,但有向非职业人群扩散的趋势。[9]
据不完全统计,近年来布病发生的公共卫生事件有2011年东北农业大学28位师生参与实验使用未经检验的山羊感染布病;飞鹤乳业11名职工诊断出职业性布鲁氏菌病;内蒙古乌兰察布市逾百检疫员感染布鲁氏菌病等等。[10] 这些事件的发生,不仅对当事人的身体健康造成影响,更值得进一步思考布病防治工作中的不足。
宋宇铮对本文亦有贡献。
参考文献
[1]https://mp.weixin.qq.com/s/3J9_74BWA0Z2Jdcy6KQc9g
[2]http://wjw.lanzhou.gov.cn/art/2019/12/6/art_4476_833332.html
[3]http://lvri.caas.cn/gywm/swjs/index.htm
[4]布病知识大问答 甘肃省疾病预防控制中心https://mp.weixin.qq.com/s/hhZ2UKO8c690Z9kg0SGHXw
[5]中华人民共和国卫生行业标准-布鲁氏菌病诊断(WS 269—2019)
[6]新京报 官方介入调查中国农科院兰州兽研所学生疑染传染病 http://www.bjnews.com.cn/news/2019/12/06/658756.html
[7]布鲁菌病诊疗专家共识 .中华传染病杂志2017年12月
[8]赵永利,王大力,冮森林 . 2005-2006 年布氏菌病全国监测报告[J]. 中国地方病防治杂志,2008,23(1)
[9]关宏 席进孝 王鼎盛 周晓燕 周巧玲 赵琦.2018年甘肃省人间布鲁氏菌病疫情分析[J] 疾病预防控制通报 2019年11月
[10]崔步云 关注中国布鲁杆菌病疫情发展和疫苗研究[J] 中国地方病学杂志2012年第31卷第4期
制版编辑 | 皮皮鱼